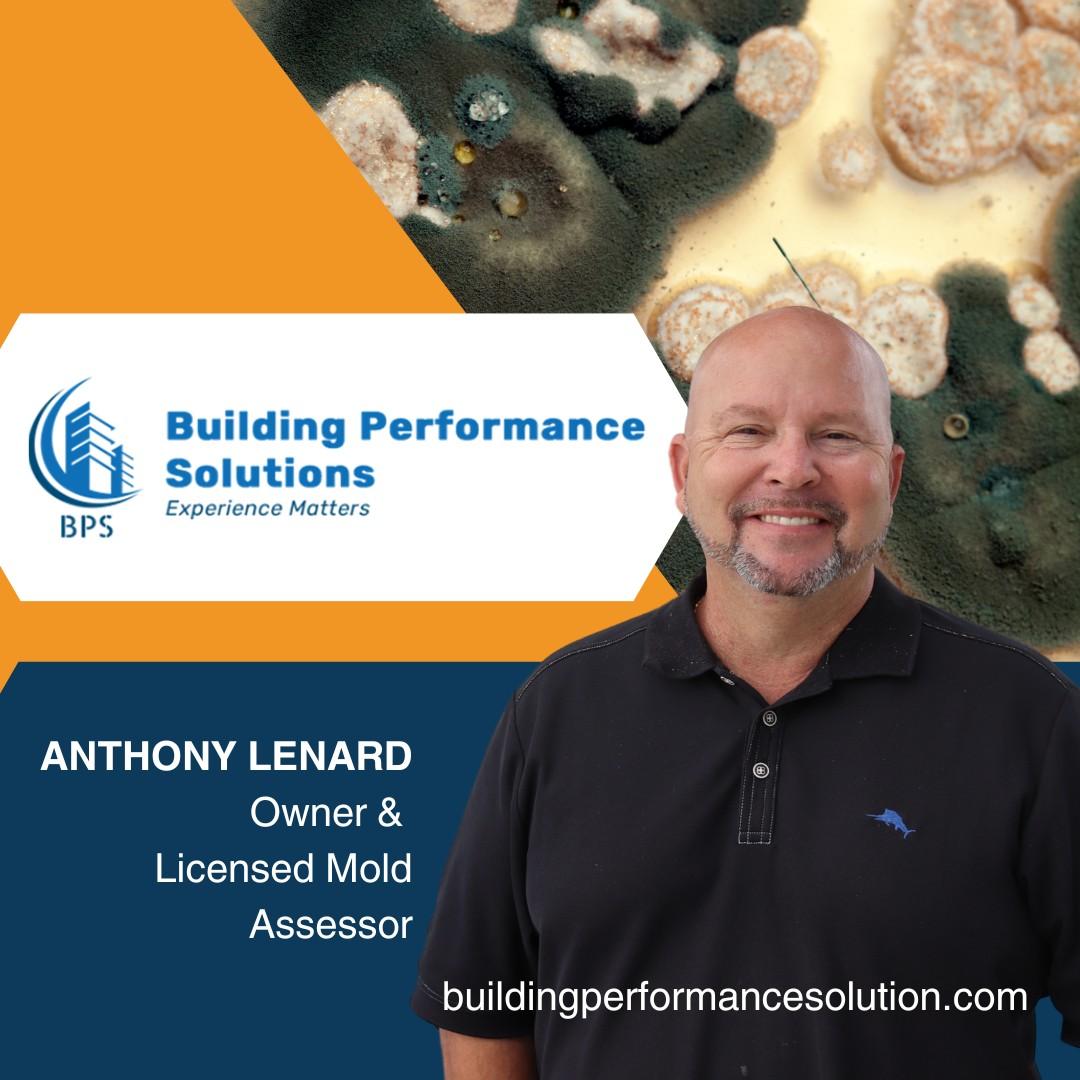

Building Performance Solutions (BPS) Helps Local Developers Combat Mold in New Construction Projects
SARASOTA FL- Building Performance Solutions (BPS), the leading provider of building consulting services has successfully assisted a local developer in mitigating mold issues in new construction projects in Sarasota and Manatee Counties.
Mold growth in building construction is a common yet often overlooked problem. It can occur when organic materials, environmental factors, and inadequate construction practices converge, leading to potential health risks for occupants and legal liabilities for builders.
BPS worked closely with the developer to identify and address the root causes of mold growth during construction. By implementing effective moisture management strategies, ensuring proper ventilation, and conducting thorough inspections, BPS helped the developer prevent mold infestation in their homes.
“Mold growth during construction is a serious concern that can impact the health of occupants and the integrity of the building,” said Anthony Lenard, owner and licensed Mold Assessor at Building Performance Solutions. “Our team is dedicated to providing comprehensive solutions that address the underlying causes of mold growth, ensuring a safer and healthier environment for all.”
Mold in building construction or remodels are two things that go together but are usually not given a lot of attention. Building construction or remodels often presents the ideal environment for mold to grow. This can happen when building materials with organic content, environmental factors, and poor building construction procedures converge. If mold is found on the materials at a site and those materials are subsequently used in the construction, the mold problem can continue in the new building. This exposes the building’s occupants to health issues and the builder to legal liabilities.
When erecting or remodeling a building, preventing mold can save the builder and owner a lot of trouble during construction. Mold is a type of fungus that thrives in damp and humid environments with organic materials that the organism can feed on. Mold can grow in finished buildings and on stacked construction materials if the conditions for its growth are present. Organic construction materials such as wood products and sheetrock easily support mold growth. Paper and dust will also promote mold growth. When mold-infested building materials are used in a building, the mold problem will often continue in the completed structure. This typically happens due to pressure differentials in the building.
If mold grows on a building’s structures or items inside it, the people who live or work there will be exposed to several health risks. Health issues that could result from mold exposure include nausea, tiredness, and worsening of symptoms in people with respiratory challenges. What causes mold to grow during building construction? The main cause is water incursion that is not handled properly.
This may be due to problems with:
· site drainage, such as when water is allowed to build in certain areas.
· stored building materials that are not adequately protected from rain and weather exposure, leading to installed materials becoming wet.
· Suppliers fail to ensure that materials are well-dried before being delivered to the site.
· Contractor’s failure to treat mold-infested materials before using them in the building.
· Poor building design.
Through its proactive approach and expertise in building science, Building Performance Solutions has become a trusted partner for developers seeking to enhance the quality and durability of their construction projects.
For more information about Building Performance Solutions and its services, visit buildingperformancesolution.com
tel:941-444-6353